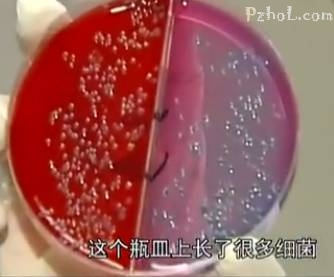

攀枝花近来天气越来越热
正是吃菠萝的好季节
街头巷尾出现了不少卖菠萝的小摊
它以独特的酸甜口感、丝丝的淡雅香味
俘获吃货们的心
消除夏日那种厌食之感
都会忍不住买来解馋

吃菠萝的好处您知道吗
1.帮助消化
菠萝吃起来酸酸甜甜,有开胃助消化的作用,他之所以有助于消化,主要得益于菠萝蛋白酶的作用,这种酶在胃中可以帮助分解蛋白质,补充人体内消化酶的不足,使消化不良的人恢复正常的消化机能。
2.辅助减少患心脏病的风险
经常适量吃菠萝避免患心脏病,因为菠萝果汁中含有一定量的生物甙和菠萝蛋白酶,不仅可以使血凝块而消散,还可以及早制止血凝块而形成,因此吃菠萝对由于血凝块而导致的冠状动脉硬化和脑动脉血管栓塞引起的心脏病,具有缓解的功效。
3.预防便秘
便秘发生的原因之一与饮食中膳食纤维的量不够有关系,菠萝中含有大量的食物纤维到达肠道之后,帮助胃肠道蠕动促进体内垃圾排出体外,有预防便秘的作用,同时可以消除身体里毒素有塑身、美容之功效。

教您选购菠萝:
一看☟☟☟:
看菠萝的叶子颜色,表面鳞叶呈橙黄色的,一般为九分熟,适合当天吃。而呈亮黄色,两端微带青绿光泽的,多为八分熟,买回去放两天再吃比较合适。
二摸☟☟☟:
通过轻轻按压菠萝的鳞叶,如果一压就出汁 则为熟烂了,如果按下去,稍微有点软,但是有一定的弹性,这种的一般就是可以食用的熟菠萝。如果按下去硬硬的,那么,就是未成熟的。
三闻☟☟☟:
熟得刚刚好的菠萝会有一股淡淡的清香,但如果这个菠萝你还没打开,就闻到了它浓重的香味,那就最好不要买了,基本上就是熟过了。
菠萝和凤梨您会区分吗?
凤梨的叶子是平的
没有那些像锯齿一样的东西
而菠萝的叶子锯齿是很明显的
摸起来像是要割破手的感觉
☟☟☟

凤梨削开之后我们就可以发现
它是没有那些刺根的
不用再剜掉那些黑黑的部分
可是菠萝削开之后
还要剜掉刺根才可以吃
☟☟☟

凤梨的皮是呈那种浅绿色的
看起来淡淡的
而菠萝则是那种黄色的
☟☟☟

凤梨是那种切开之后
洗洗就可以直接吃的
而菠萝则是必须用盐水泡一下才可以吃
要不然会不甜的
☟☟☟

Tips:
虽然凤梨和菠萝不是同一种水果,
但是在生物学上却属于同一类水果,
两者都有较高的营养成分,
因此,无论是购买哪一种都对人体有益!

我们经常能看到一个摊贩正在削菠萝
摊贩的手拿了各种水果及箱子后
甚至数过钱后都不洗手
依然在削菠萝
再把塑料袋套在菠萝上
等待顾客前来选购

很多人为了方便
也直接就选择了已削皮的菠萝
◆◆◆◆◆
卫生监督部门工作人员说
菠萝的果肉长时间暴露在空气中容易滋生细菌
套上方便袋看似干净了
但果肉被包裹在方便袋中更容易滋生细菌
带皮的菠萝基本没有细菌
☟☟☟


路边买来的菠萝却培养出许多细菌
☟☟☟

一些胃肠比较敏感的人
食用后会引起呕吐、腹泻等不良反应
建议大家最好还是选择购买带皮的菠萝
回家自己削皮浸泡,或是购买时现削皮
◆◆◆◆◆
菠萝中含有一种叫菠萝蛋白酶的物质
有人会对这种物质产生过敏反应
把菠萝切成片或块放在盐水中浸泡30分钟
然后再洗去咸味
就可以达到消除过敏性物质的目的
还会使菠萝味道变得更加甜美
知道了上面这些小知识
大家可以有意识地买一些菠萝回家吃
能够对我们的身体
起到很好的保护作用哦~
精彩回顾

 “人大代表之家”的大能量
“人大代表之家”的大能量 合作意向47.5亿元现场签约15.6亿元 “
合作意向47.5亿元现场签约15.6亿元 “![[攀枝花学院] 《中国教育报》:专题报道我校大学生思想政治教育工作创新做法](http://www.pzhol.com/d/file/p/2018/11-07/f172e634b00e8f493225a85489f1e101.png) [攀枝花学院] 《中国教育报》:专题报道
[攀枝花学院] 《中国教育报》:专题报道![[攀枝花学院] 医学院:举办读书交流分享会活动](http://www.pzhol.com/d/file/p/2018/11-07/96c574a09372362e3b445fd1b88229b5.png) [攀枝花学院] 医学院:举办读书交流分享
[攀枝花学院] 医学院:举办读书交流分享 抓人才培养 促行业发展——东区开展201
抓人才培养 促行业发展——东区开展201![[攀枝花学院] 向党外人士通报第二次党代会会议精神](http://www.pzhol.com/d/file/p/2018/11-07/eae90462cd666c52566e85225ba29011.jpg) [攀枝花学院] 向党外人士通报第二次党
[攀枝花学院] 向党外人士通报第二次党 横穿马路,再穿绿化带,出行极不方便!花城大
横穿马路,再穿绿化带,出行极不方便!花城大 四川政务服务热线统一呼叫“12345”
四川政务服务热线统一呼叫“12345” 消费者"差评权"不容忽视
消费者"差评权"不容忽视 “蹭暖费”违背消费自愿平等原则
“蹭暖费”违背消费自愿平等原则